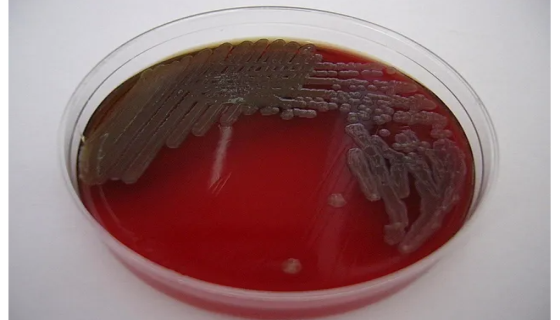
嗜麦芽窄食单胞菌的诊断标准与试验结果！
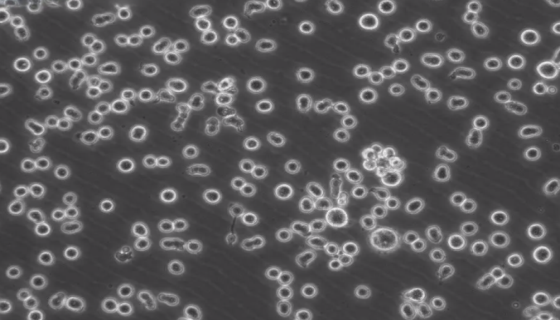
小鼠T淋巴细胞的培养步骤与应用！

CALU-3 人肺腺癌细胞的应用与培养步骤!
CALU-3人肺腺癌细胞是从一名25岁的白人男性肺腺癌患者的...

大鼠角膜内皮细胞的背景与应用!
大鼠角膜内皮细胞是将角膜组织酶解法制备而来,vWF、Fact...

分枝杆菌的知识解析与形态特征及主要分类!
分枝杆菌属(Mycobacterium)是一类细长略弯曲的,...

短双歧杆菌的菌株特点与认识过程及适用人群!
短双歧杆菌Bifidobacterium是1899年由法国学...

霍乱弧菌的发病因素与诊断预防及检测方法!
霍乱弧菌(Vibrio cholerae)是革兰氏阴性菌,菌...

MPC-83(小鼠胰腺腺泡细胞)培养的优点与处理方法!
小鼠胰腺腺泡细胞分离自胰腺组织;胰腺分为外分泌腺和内分泌腺两...
嗜麦芽窄食单胞菌的诊断标准与试验结果!
嗜麦芽窄食单胞菌广泛存在于自然界中,也可寄居于人的呼吸道和肠...

海洋分枝杆菌的菌落特征与临床表现及诊断治疗!
海洋分枝杆菌原名Mycobacterium marinum,...
小鼠T淋巴细胞的培养步骤与应用!
小鼠T淋巴细胞是骨髓来源的淋巴干细胞在胸腺内分化而成的。胸腺...